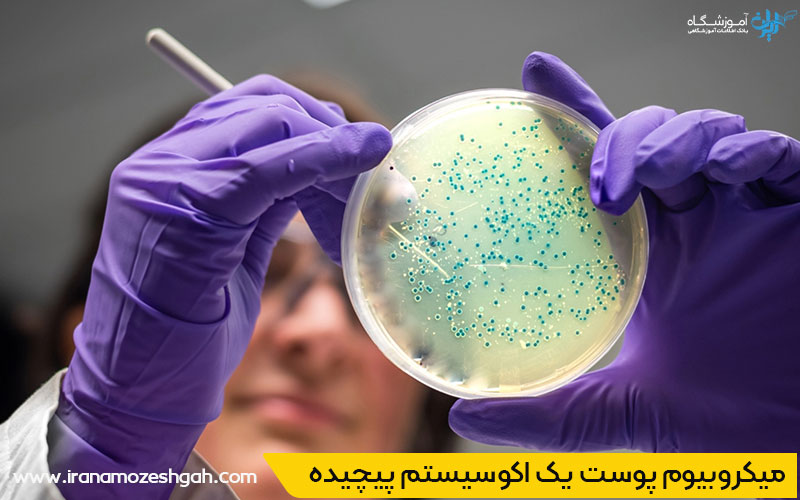
میکروبیوم پوست در سلامت پوست

میکروبیوم و تاثیر آن بر زیبایی و سلامت
شاید شگفتزده شوید اگر بدانید که روی پوست شما یک اکوسیستم زنده و پیچیده از تریلیونها میکروارگانیسم در حال زندگی است. درک تاثیر میکروبیوم پوست در سلامت و زیبایی یکی از جدیدترین و مهمترین دستاوردهای دنیای علم پوست است. این جامعه نامرئی از باکتریهای خوب، مانند یک سپر دفاعی زنده عمل کرده و نقشی حیاتی در شفافیت، شادابی و مقاومت پوست شما دارد. شناخت این دنیای پنهان و یادگیری روشهای مراقبت از آن، کلید دستیابی به پوستی سالم و درخشان است.برای تبدیل شدن به یک فیشیال کار حرفه ای در تهران یا سایر شهر های ایران بهتر است با تمامی نکات تخصصی پوست و تاثیر آن بر نتیجه کارتان آشنا باشید.
میکروبیوم پوست چیست؟
پوست ما تنها یک سطح بیجان نیست، بلکه میزبان یک جامعه متنوع از باکتریها، قارچها و ویروسهاست که در مجموع میکروبیوم پوست نامیده میشوند. این میکروارگانیسمها در یک رابطه همزیستی با ما زندگی میکنند و برای سلامت پوست ضروری هستند. تصور کنید پوست شما یک باغ پر از گیاهان مختلف است؛ میکروبیوم متعادل مانند یک باغ سرسبز و سالم است که در آن گیاهان مفید اجازه رشد به علفهای هرز (باکتریهای بیماریزا) را نمیدهند و از خاک (پوست) محافظت میکنند.
میکروبیوم پوست یک اکوسیستم پیچیده و منحصربهفرد برای هر فرد است، درست مانند اثر انگشت. این جامعه میکروبی از بدو تولد شکل میگیرد و تحت تأثیر عواملی مانند ژنتیک، سبک زندگی، رژیم غذایی و محیط زندگی تغییر میکند. وجود این میکروارگانیسمها روی پوست نه تنها طبیعی، بلکه حیاتی است. آنها اولین خط دفاعی بدن ما در برابر عوامل بیماریزای خارجی هستند و نقش مهمی در آموزش سیستم ایمنی بدن ما دارند. درک این مفاهیم پایه، در هر آموزش فیشیال صورت مدرن و علمی ضروری است. برای آشنایی با نکات تخصصی پاکسازی پوست و فیشیال تمامی موارد آموزشی را میتوانید در یک دوره آموزشی در آموزشگاه فیشیال پوست در تهران به صورت کامل یاد بگیرید.
وظایف کلیدی میکروبیوم: از سد دفاعی تا تنظیم pH
این جامعه میکروسکوپی وظایف مهمی بر عهده دارد که به طور مستقیم بر سلامت و ظاهر پوست ما تأثیر میگذارد. آنها با تولید پپتیدهای ضدمیکروبی، از رشد باکتریهای مضر جلوگیری میکنند. همچنین با تجزیه لیپیدهای پوست، به حفظ رطوبت و تقویت سد دفاعی آن کمک میکنند. یکی دیگر از نقشهای حیاتی آنها، حفظ pH اسیدی پوست (بین ۴.۵ تا ۵.۵) است. این محیط اسیدی برای فعالیت آنزیمهای مفید پوست ضروری است و از رشد بسیاری از پاتوژنها جلوگیری میکند.

نقش عدم تعادل میکروبیوم در بروز مشکلات پوستی مانند آکنه و اگزما
وقتی تعادل این اکوسیستم ظریف به هم میخورد (وضعیتی که به آن دیسبیوزیس میگویند)، مشکلات پوستی آغاز میشوند. برای مثال، در بیماری آکنه، رشد بیش از حد یک نوع باکتری به نام Cutibacterium acnes باعث التهاب و ایجاد جوش میشود. در افراد مبتلا به اگزما (درماتیت آتوپیک)، تنوع میکروبیوم به شدت کاهش یافته و جمعیت باکتری مضر استافیلوکوکوس اورئوس افزایش مییابد که به خشکی، خارش و التهاب دامن میزند. درک تاثیر میکروبیوم پوست در سلامت و زیبایی به ما کمک میکند تا به جای مبارزه با علائم، ریشه این مشکلات را هدف قرار دهیم.

روشهای تقویت میکروبیوم: چگونه از باکتریهای خوب پوست خود مراقبت کنیم؟
مراقبت از میکروبیوم پوست به معنای فراهم کردن شرایطی است که در آن باکتریهای مفید بتوانند رشد کنند و جامعهای متعادل و قوی بسازند. این کار نیازمند یک رویکرد ملایم و حمایتی است. استفاده بیش از حد از محصولات آنتیباکتریال قوی، لایهبرداریهای مکرر و خشن، و شستشوی زیاد میتواند این اکوسیستم را نابود کند. هدف ما باید پاکسازی پوست از آلودگیها باشد، نه استریل کردن آن.
جدول روشهای تقویت میکروبیوم پوست
| روش تقویت میکروبیوم پوست | توضیح تخصصی | اهمیت و تاثیر بر سلامت پوست |
|---|---|---|
| پاکسازی ملایم | استفاده از شویندههایی با pH متعادل و بدون سولفاتهای قوی که چربیها و باکتریهای مفید پوست را حفظ میکنند. | حفظ تعادل طبیعی میکروبیوم و جلوگیری از آسیب به سد دفاعی پوست. |
| حفظ رطوبت | کاربرد مرطوبکنندهها برای تقویت سد پوستی و ایجاد محیط مناسب برای رشد باکتریهای مفید. | تقویت سلامت پوست و افزایش مقاومت در برابر عوامل مخرب محیطی. |
| پرهیز از محصولات خشن | کاهش مصرف اسکرابهای زبر و محصولات حاوی الکل بالا که میتوانند به باکتریهای مفید آسیب برسانند. | جلوگیری از تخریب میکروبیوم و تحریک پوست. |
| مدیریت استرس | کاهش استرس مزمن که میتواند تعادل میکروبیوم پوست و روده را به هم بزند. | حفظ تعادل زیستی پوست و بهبود سلامت کلی بدن. |
محصولات مراقبتی و تاثیر میکروبیوم پوست در سلامت و زیبایی
صنعت زیبایی به سرعت در حال درک اهمیت این موضوع است و محصولاتی با عنوان میکروبیوم-فرندلی (Microbiome-Friendly) در حال افزایش هستند. این محصولات با هدف حمایت و تغذیه باکتریهای مفید پوست طراحی شدهاند. هنگام انتخاب محصولات، به دنبال ترکیباتی باشید که به جای مبارزه با پوست، با آن همکاری میکنند. درک عمیق این موضوع، یکی از مهارتهای کلیدی است که در یک دوره فیشیال صورت حرفهای آموزش داده میشود و یک متخصص را از دیگران متمایز میکند.

۱. انتخاب شوینده مناسب
شوینده شما میتواند دوست یا دشمن میکروبیوم پوستتان باشد. شویندههای قلیایی و قوی، pH پوست را به هم میریزند و تمام باکتریها، اعم از خوب و بد را از بین میبرند. این کار پوست را آسیبپذیر و مستعد خشکی و التهاب میکند. به دنبال شویندههایی باشید که به طور مشخص دارای pH متعادل (حدود ۵.۵) هستند و از سورفکتانتهای ملایم در آنها استفاده شده است. هدف، پاک کردن آلودگی و آرایش است، نه از بین بردن اکوسیستم طبیعی پوست.
۲. نقش پروبیوتیکها، پریبیوتیکها و پستبیوتیکها در محصولات مراقبتی
شما احتمالا با پروبیوتیکها در ماست آشنا هستید، اما آنها در محصولات پوستی نیز کاربرد دارند. پروبیوتیکها، باکتریهای زنده و مفیدی هستند که به صورت موضعی استفاده میشوند. پریبیوتیکها، فیبرهای گیاهی هستند که به عنوان غذا برای باکتریهای خوب عمل کرده و به رشد آنها کمک میکنند. پستبیوتیکها نیز ترکیبات مفیدی هستند که توسط باکتریهای خوب تولید میشوند (مانند اسید لاکتیک) و به سلامت پوست کمک میکنند. محصولاتی حاوی این ترکیبات میتوانند به بازگرداندن تعادل میکروبیوم کمک کنند.

ایران آموزشگاه: دروازه ورود به دنیای تخصصی مراقبت از پوست
علم میکروبیوم نشان میدهد که مراقبت از پوست بسیار فراتر از استفاده از چند کرم ساده است. اگر این دنیای شگفتانگیز شما را به وجد آورده و میخواهید دانش خود را به سطح تخصصی برسانید، ایران آموزشگاه بهترین نقطه شروع برای شماست. در این پلتفرم میتوانید به سادگی به جستجو و مقایسه انواع دوره آموزش فیشیال صورت از بهترین آموزشگاههای کشور بپردازید. بهترین آموزش فیشیال صورت را که با اهداف شما همسو است پیدا کنید و مسیر حرفهای خود را در دنیای پویای سلامت و زیبایی پوست آغاز نمایید.
سوالات متداول
۱.آیا صابون آنتیباکتریال برای میکروبیوم پوست مضر است؟
بله، استفاده مکرر از صابونهای آنتیباکتریال قوی میتواند باکتریهای مفید را از بین ببرد و تعادل میکروبیوم را مختل کند که منجر به خشکی و حساسیت میشود.
۲.آیا مصرف مکملهای پروبیوتیک خوراکی به پوست کمک میکند؟
بله، سلامت میکروبیوم روده ارتباط مستقیمی با پوست دارد. مکملهای پروبیوتیک با تقویت باکتریهای خوب روده، میتوانند به کاهش التهاب و بهبود شرایطی مانند آکنه و اگزما کمک کنند.
۳.از کجا بفهمم میکروبیوم پوست من نامتعادل است؟
علائمی مانند خشکی مداوم، قرمزی، حساسیت، جوشهای مکرر یا کدری پوست که به درمانهای معمول پاسخ نمیدهند، میتواند نشانهای از عدم تعادل میکروبیوم باشد.




بدون دیدگاه